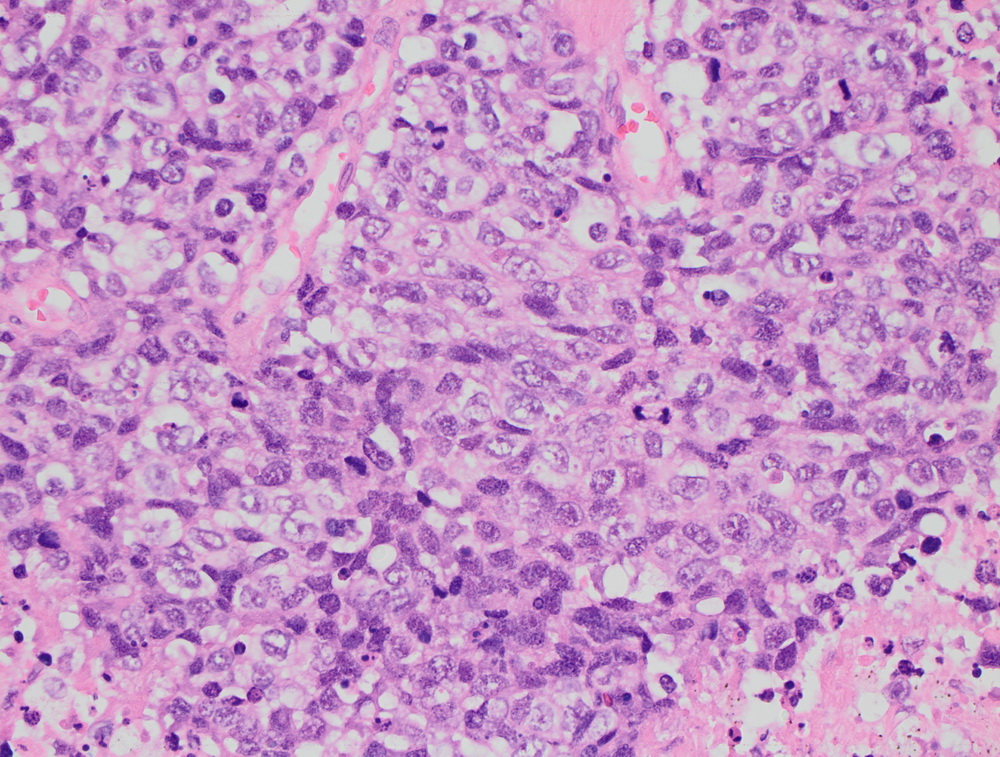
kno.jpg

Как проводится гистологическое исследование: виды, методы, особенности
Злокачественные новообразования - это группа заболеваний, насчитывающая несколько тысяч видов опухолей разных типов и разной степени злокачественности. Они подразделяются на большие группы в зависимости от того из каких тканей они развиваются: если из эпителиальных (барьерных) - то это раки, если из соединительных тканей (мягких тканей и костей) – саркомы, если из лимфоидных (иммунных) – лимфомы/лейкозы. От того насколько правильно верифицирована опухоль (определен ее тип, степень злокачественности и другие характеристики) зависит правильность и эффективность лечения. Важную роль в этом играют гистологические исследования. О том, как проходят гистологические исследования, какие задачи кроме диагностических они позволяют решать, что влияет на сроки их выполнения рассказывает заведующая патологоанатомическим отделением с прозектурой НМИЦ онкологии им. Н.Н. Петрова, к.м.н. Анна Сергеевна Артемьева.
Что служит материалом для патоморфологических (гистологических) исследований?
Процесс получения фрагмента ткани (биоптата) - биопсия – это несколько разных способов забора материала для гистологического исследования. Виды биопсии:
- Пункционная биопсия – «тычок», тонкой или толстой иглой. Пункционные биоптаты редко имеют диаметр больше 1-2 мм.
- Ножевая биопсия – открытая или эндоскопическая (малоинвазивная), в том числе лапароторако-медиастиноскопия.
Биопсию внутренних органов делают под УЗИ-навигацией, либо с помощью хирургического вмешательства.
Как обрабатывают эти материалы для проведения гистологического исследования?
1 Этап. Фиксация - «консервирование» биоптата в формалине - специальном химическом растворе, который предотвращает гниение, позволяет сохранить структуры ткани. Фиксация биоптата может занимать от 6 до 24 часов – в зависимости от его вида и размера. Операционный материал фиксируется дольше, в несколько этапов. Сначала предварительная фиксация, которая занимает примерно 12 часов. Затем вырезка нужных фрагментов и повторная фиксация еще 24 часа. Соотношение объема материала к объему формалина должно быть 1:20.
2 Этап. Процессинг - процесс обезвоживания, обезжиривания и пропитки материала парафином. Автомат перемещает кусочек материала из раствора в раствор. В качестве растворов применяются: абсолютированный изопропиловый спирт (6-8 смен), ксилол (2 смены), расплавленный парафин (2 смены). Программа разнится для «жирного» материала (к которым относятся, например, ткани молочной железы) и «нежирного» – 36 и 24 часа соответственно.

Процесс получения парафиновых блоков.
3 Этап. Изготовление парафинового блока. Кусок материала помещается в форму с расплавленным парафином (уже другим нежели во время процессинга – с более высокой температурой плавления) и охлаждается. Выполняется вручную, сложно ускорить.

Микротомия
4 Этап. Изготовление срезов. Толщина образца - кусочка ткани, залитого в парафин – 1-3 мм. Толщина каждого среза 4-5 мкм (0,004-0,005 мм). Выполняет лаборант с использованием специального инструмента – микротома. Срезы монтируются на стекла и должны высохнуть. Несмотря на то, что часть материала теряется при выравнивании в микротоме, при должном профессионализме, из одного образца - материала от одной биопсии, операционного материала от одной опухоли, возможно изготовить около 100 стекол (микропрепаратов).
Для чего делаются срезы?
Срезы делаются для рутинной окраски гематоксилинном и эозином, иммуногистохимического исследования и других видов исследований. Срезы для всех исследований используются одинаковые, различается окраска, могут отличаться стекла, на которые они монтируются, так для ИГХ и FISH нужны специальные адгезивные стекла или заряженные стекла.

Гистостейнер
Блоки и стекла способны храниться долгие годы и использоваться для проведения дополнительных гистологических исследований, пересмотров, а также в научных целях.

Архив
Архив гистологических материалов собирается в НМИЦ онкологии им. Н.Н. Петрова с 1927 года и содержит более 10 млн единиц хранения (микропрепараты - стекла, парафиновые блоки, архивные карточки, влажный архив).
Какие виды гистологических исследований наиболее информативны?
- Гистологическое исследование
- Иммуногистохимия (ИГХ)
- Флуоресцентная гибридизация in situ (FISH), может быть хромофобной (принцип тот же, другой тип метки)
Что позволяют определить разные виды гистологических исследований
Гистологическое исследование – что это такое?
Позволяет верифицировать опухоль – то есть определить из каких клеток она состоит (из какой ткани она развивается), степень ее дифференцировки (зрелости). Рутинная окраска, выполняющаяся при гистологическом исследовании, позволяет выявить патологический процесс в анализируемом материале (биоптате, операционном материале):
- воспаление,
- специфическое воспаление,
- аномалия развития,
- опухоль.
Также, в большинстве случаев, благодаря рутинной окраске, можно определить степень злокачественности опухоли и, если она достаточно зрелая, то какова ее природа.
Окрашенные срезы под микроскопом

Инвазивный протоковый рак er 100%. |

Карцинома сигмовидной кишки. |
Крупноклеточная нейроэндокринная опухоль. |

МТС крупноклеточной нейроэндокринной опухоли. |

Неспецифический рак молочной железы. Участок in situ карциномы внутри протока, криброзного типа. |

Низкодифферинцированный рак пищевода. |
При гистологическом исследовании биоптата и операционного материала можно оценить распространенность: размер опухоли и прорастание в окружающие ткани, насколько затронуты лимфоузлы и есть ли метастазы в отдаленные органы (если эти все структуры присланы для гистологического исследования). При консультации готовых микропрепаратов – стекол, это, как правило, невозможно, если опухоль больше размеров гистологической кассеты или рассечена предыдущим исследователем и не предоставлены данные макроскопического исследования. Во время гистологического исследования изучаются все стекла от одного образца – материала, полученного от одного вмешательства - одной операции или одной биопсии, вне зависимости от их количества, это считается одной консультацией. Сроки выполнения гистологического исследования зависят от количества микропрепаратов и от категории сложности того процесса, который в них обнаруживается, сроки могут удлиняться, особенно при необходимости использования дополнительных методов исследования и анализа дополнительных сведений. На сроки выполнения гистологического исследования влияет полнота предоставленной пациентом клинической информации, в том числе данных уже проведенных исследований.
Иммуногистохимия (ИГХ)
Сложное многоэтапное исследование, выполняется после гистологического исследования на том же материале. Опухолевые срезы окрашиваются антителами, которые способны связываться антигенами (белками), которые несут опухолевые клетки. Разные опухолевые клетки несут разные антигены, к каждому из которых подобно ключа к замку подходит антитело.

Один из этапов ИГХ
ИГХ исследование — это комбинаторика. 100% специфичных и чувствительных к какой-то опухоли маркеров не существует, но есть набор антигенов, которые в определенном типе опухоль должны быть и набор тех, которых там быть не должно, таким образом ИГХ-панель строится так чтобы включать несколько антител, которые должны быть позитивны и несколько, которые должны быть негативны. Для разных опухолей различаются эти наборы позитивных/негативных маркеров. При проведении прогностической ИГХ – выявлении маркеров чувствительности к терапии определяется набор таких маркеров для конкретных опухолей, например, рака молочной железы: рецепторы стероидных гормонов (эстроген, прогестерон), рецептор эпидермального фактора роста (HER2) и индекс пролиферативной активности Ki67 (скорости деления клеток). Стекла окрашиваются последовательно - различными антителами красятся наборы маркеров в несколько этапов, процесс окраски стекол одним антителом занимает 48 часов. Таким образом, каждое антитело наносится на отдельный срез ткани, монтированный на отдельное стекло, как правило с соответствующим внешним контролем, количество реакций (используемых антител) и этапов окраски может существенно варьировать в зависимости от конкретной диагностической ситуации, все зависит от индивидуальных особенностей опухоли. Проводится такое количество окрасок, которое необходимо для того, чтобы выявить наиболее характерный для определенной опухоли набор позитивных и негативных маркеров. Кому-то для этого будет достаточно 5 антител, а кому-то необходимо сделать 20 окрасок и более. Максимальное количество окрасок, которое нам приходилось делать – 212. Поэтому точные сроки и стоимость этого исследования невозможно определить заранее. Разные по течению и прогнозу опухоли могут быть очень похожи друг на друга, только минимальные различия в окрашивании, с учетом клинических данных и данных других методов обследования, могут позволить установить верный диагноз. Есть целый ряд доброкачественных опухолей, симулирующих злокачественные, в том числе высокоагрессивные, а некоторые злокачественные высоко дифференцированные опухоли трудно отличить от воспалительных и реактивных процессов. В таких ситуациях только опыт и квалификация патоморфолога, анализ всего комплекса доступной информации (снимки КТ, МРТ, рентген, протокол операции, и др.) позволяют поставить диагноз. В грамотной интерпретации результатов ИГХ очень важна роль эксперта, ведь те случаи, с которыми приходится работать, в большинстве своем, сложные. Практически не существует антител, которые могут выступать в качестве 100%-х маркеров той или иной опухоли, врачу всегда приходится взвешивать различные вероятности.
Что определяется с помощью ИГХ?
- Наличие рецепторов гормонов прогестерона и эстрогена при раке молочной железы;
- Экспрессию HER-2/neu в клетках при раке молочной железы, раке желудка;
- Определить ходжкинские и неходжкинские лимфомы - установить точный диагноз лимфомы на сегодняшний день невозможно без применения этого вида исследования.
- Определить первичная это опухоль или метастазы, тканевую принадлежность метастазов.
Иммуногистохимия позволяет оценить потенциальный темп роста опухоли, ответ на химио-, таргетную, гормональную терапию.
Флуоресцентная гибридизация in situ (FISH-тест)
Это метод молекулярно-генетической диагностики в ткани. FISH проводится в срезе ткани и позволяет привязать генетическую перестройку к конкретной опухолевой клетке. В этом тесте также используются специальные красители, которые связываются только с определенными участками хромосом. Их называют зондами, которые могут быть помечены флуоресцентным или хромогенным красителем, визуализирующимися при помощи флуоресцентного или светового микроскопа. Технические операции по подготовке гистологических стекол к этому исследованию занимает 2 рабочих дня.

Анализ препарата с помощью многоголового микроскопа.
Полученные микропрепараты очень чувствительны к внешней среде – они могут выцвести со временем, чтобы избежать потерь информации все FISH-препараты сканируются, создается их цифровая копия, которая доступна для внешнего пересмотра. Специалисты просматривают флуоресцирующий материал в темном поле, в анализе препарата принимают участие как минимум 2 специалиста. При необходимости используется и цифровой анализ.
Что определяется с помощью FISH-теста?
FISH-тест позволят диагностировать некоторые виды опухолей, определяет целесообразность использования некоторых химиотерапевтических препаратов.
- определяется наличие амплификации HER2 в случаях пограничного результата по данным ИГХ, что необходимо для назначения таргетной терапии;
- проводится диагностика, то есть выявление генетических перестроек специфичных для определенного типа опухолей, когда невозможно окончательно установить диагноз при помощи более простых методик, чаще всего это саркомы мягких тканей и опухоли головного мозга;
- генетические отклонения, вызывающие рак того или иного органа;
- при лимфомах эта методика используется в диагностических целях и для выявления факторов неблагоприятного прогноза, то есть показаний для ранней интенсификации лечения.
Проведение гистологического исследования, и в первую очередь FISH-теста - это экспертная работа, которая зависит от квалификации специалиста. Очень многие мутации, которые выявляются в опухолях, не всегда являются метками опухолей, они могут находиться и в доброкачественных образованиях или нормальных тканях. За год патологоанатомическое отделение НМИЦ онкологии имени Н.Н. Петрова выполняет около 20000 гистологических исследований (пациентов), из них около 5000 консультативных случаев (пересмотров), более 30000 ИГХ исследований, а также участвует в программе внешнего контроля качества ИГХ исследований NordIQ. Специалисты отделения обладают огромным опытом проведения гистологических исследований и экспертными компетенциями.
Скорость выполнения гистологических исследований и адекватность гистологического заключения зависят от ряда факторов:
- Качества стекол и блоков;
- Комплектности предоставления стекол (необходимо предоставить все стекла и блоки);
- Предоставление пациентом дополнительной информации, которая поможет верно интерпретировать данные гистологического исследования, ИГХ и FISH-теста, а именно: данные анамнеза заболевания, данные о сопутствующих заболеваниях, в первую очередь инфекционных (ВИЧ, гепатиты); все данные всех проведенных обследований и вмешательств: снимки - рентген, КТ, МРТ, УЗИ, протоколы операций, выписки.
После выполнения гистологического исследования пациент получает гистологическое заключение/протокол исследования гистологического материала.
Расшифровка гистологического исследования: на что обратить внимание?
Гистологическое заключение включает в себя несколько рубрик (полей):
Макроскопическое описание
Заполняется как для биоптатов - не обязательно, так и для операционного материала, для которого имеет крайне важное значение в ряде случаев.
Микроскопическое описание
Описание изменений на микроскопическом уровне, не обязательно к заполнению, так как вся необходимая информация может быть отражена в поле «заключение».
Результаты иммуногистохимического исследования
В этом поле описано какие антитела использовались в данном случае и каков результат окрашивания: наличие окрашивание или его отсутствие, локализация в клетке при необходимости, а также процент позитивных клеток и интенсивность реакции, когда это имеет значение.
Патологоанатомическое заключение
Содержит нозологическую/классификационную единицу, если ее возможно установить по исследованному материалу, то есть дает ответы на вопросы:
- Это первичная опухоль или метастаз?
- Где локализован первичный опухолевый очаг?
- Каков гистологический тип опухоли (из клеток какого типа она состоит).
Также приводятся все необходимые прогностические данные: степень дифференцировки, параметры, влияющие на стадию, состояние краев резекции, если возможно их оценить и т.п.
Дополнительные замечания и рекомендации
Поле может содержать комментарии, относительно возможного направления дальнейшего обследования, вероятности того или иного диагноза, необходимости ознакомиться с теми или иными клиническими данными и др.
Если вы хотите узнать побольше о бесплатных возможностях ФБГУ НМИЦ онкологии им. Н.Н. Петрова Минздрава России, получить очную или заочную консультацию по диагностике и лечению, записаться на приём, ознакомьтесь с информацией на странице.
Если вы хотите общаться с нами через социальные сети, обратите внимание на аккаунты в ВКонтакте и Telegram.
- Плоскодетекторная компьютерная томография в интервенционной радиологии: фундаментальные принципы, современные технологии и перспективы дальнейшего развития
- Может ли экстракорпоральное оплодотворение спровоцировать рак?
- Внутрибольничная пневмония: диагностика, лечение и профилактика
- Рак и наследственность
- Профессор Светлана Кулева: «До сих просыпаюсь от страха, что иду на экзамен по взрослой хирургии»






